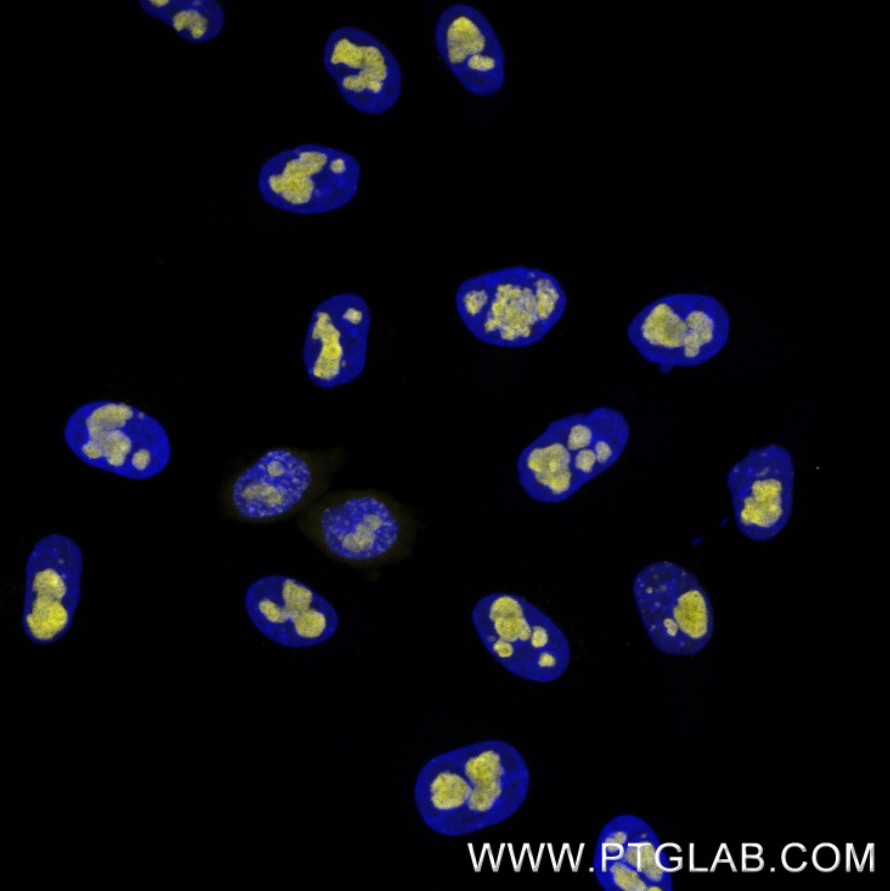

Validation Data Gallery
Product Information
FlexAble Oligo-Ready Kits provide a quick and efficient method for labeling antibodies with oligos using FlexAble Antibody Labeling Technology. It uses high-affinity, Fc-specific (species & subtype specific!) labeling reagents called FlexLinkers, which carry 1 or 2 azide groups that react with DBCO-oligos through click chemistry. Following conjugation, Oligo-FlexLinker conjugates enable rapid, site-specific and high-affinity labeling of antibodies, ensuring consistent and reliable performance.
The idea is to have a set of Oligo-FlexLinkers ready for quick labeling via the fast & easy FlexAble protocol (Part 2 of the protocol).
The protocol is divided into 2 parts (for detailed instructions, please refer to the full protocol):
Part 1: Preparation of Oligo-FlexLinkers
DBCO-functionalized ssDNA oligo reacts to DBCO-ready FlexLinkers, carrying 1 or 2 azide groups for Azide-DBCO click conjugation, to generate Oligo-FlexLinkers. The protocol includes a clean-up step to remove excess free oligo.
1 Kit provides enough conjugation-ready FlexLinker for conjugation of up to 3 different Oligos to FlexLinker (scalable from 3x 33 µg – 1x 100 µg).
Oligo-FlexLinkers are stable and can be stored at -20°C for up to 6 months.
Part 2: Labeling of Antibodies with Oligo-FlexLinkers
Oligo-FlexLinkers are used to label primary antibodies in a simple 15 min protocol with minimal hands-on time.
The intermediate product, the Oligo-FlexLinker, can be stored at -20°C (for up to 6 months) or used directly to label the desired amount of primary antibody.
You can label as little as 0.5 µg of primary antibody per reaction, enabling you to label up to 200 different primary antibodies with one kit or scale up according to your needs (labeling up to 100 µg of one antibody).
Our FlexAble system is compatible with primary antibodies in any common storage buffer (incl. BSA, preservatives, Tris, glycerol) at any concentration. A buffer exchange for your primary is not required.
For questions, please refer to the FAQ on the product pages of the Kits, or contact our Technical-Support.
IMPORTANT NOTE:
The current version of this kit does not contain all reagents you will need for the protocol. The following reagents must be sources seperately, most of it might be available in your lab already.
| Reagent | Amount | Used for |
| DBCO-Oligo | 10 or 20 nmol (for 1 or 2 azide respectively) for 1/3 of the kit (scale up to your needs; examples see next page) | Conjugation to FlexLinker |
Ni-NTA Agarose (e.g.. Protino Ni-NTA Agarose Macherey-Nagel, 745400.25) | 100 µl for 1/3 of the kit (scale up to your needs) | Removal of free DNA, Oligo-FlexLinker binds to Ni2+ via His-tag |
| PBS (Nuclease free) | 5 ml per Oligo-FlexLinker conjugation | Washing steps |
| Imidazole (1M stock) | 1 ml per Oligo-FlexLinker conjugation | Elution Buffer |
Desalting columns (e.g., Zeba™ Spin Desalting 2 mL Columns, Thermo, 89890) | 1x per Oligo-FlexLinker conjugation | Imidazole removal |
| Product name | FlexAble 1x Oligo-Ready Antibody labeling Kit for Mouse IgG1 (DBCO or Amine ready) |
| Assay type | Antibody Labeling with DBCO functionalized Oligos or other DBCO functionalized molecules |
| Species Reactivity | Mouse IgG1 |
| Conjugate | 1x Azide (DBCO or Amine ready) |
Kit Components
| Component | Size |
|---|---|
| FlexBuffer | 2000ul |
| FlexQuencher for Mouse IgG1 | 400ul |
| Oligo-Ready FlexLinker 1x Azide (DBCO or Amine ready) for Mouse IgG1 | 50ul |
| Spin columns | 3*1pcs |
Ship Condition
Shipped on blue iceStorage Condition
Kit storage: Store for 1 year at -20°C or for 6 months at +4°C upon receipt. Oligo-FlexLinker conjugate storage: Store for up to 6 months at -20°C or for -80°C for 1 year+.FAQ
How many Oligos can I attach to one FlexLinker?
We offer options for conjugation with either 1 or 2 Oligos per FlexLinker / Antibody. The 2x Oligo-Ready version will yield a Linker with a DOL between 1-2, depending on the conjugation efficiency. Custom options (e.g. 5 Oligos) are available upon request. Please contact our Tech-Support.
What kind of antibodies can I label with these Kits?
There are almost no limitations to the antibody you can use. The FlexAble labeling protocol tolerates low concentrations, a wide range of buffer conditions, BSA, and glycerol. This makes our Oligo-Ready kit compatible with Antibodies from most vendors and works without prior buffer exchange.
Do I need any additional reagents or equipment?
Yes. For this basic FlexAble Oligo-Ready Antibody Conjugation Kit you will need to source some of the material (like Ni²⁺ beads, Imidazole, desalting columns) from other sources. Please refer to the the Manual – each chapter will provide you with detailed information about the required components. You might have most of it in your lab already!
What’s the minimum amount of antibody I can label with this kit?
Our 100 μg kits can be used for generation of up to 3 different Oligo-FlexLinkers (intermediate product). After preparation of the Oligo-labeled FlexLinker, you can use this product to label up to 100 μg of primary antibody in total. As little as 0.5 μg of primary antibody are required per reaction, giving you maximum flexibility to label small amounts of antibody (up to 200x 0.5 μg antibody per kit).
How can I scale this reaction up or down?
Intermediate product: Conjugations of your desired oligo to the Oligo-Ready FlexLinker; the conjugation can be scaled up from 3 × 33 μg of FlexLinker to 1 × 100 μg of FlexLinker in steps that suit your experimental needs.
Final labeling of antibody: Labeling of primary antibody with Oligo-FlexLinker; the labeling can be scaled up in multiples of 0.5 μg of primary antibody. With a 100 μg Kit, you can label up to 100 μg of antibody in one reaction, or 200 different antibodies in 200 small reactions (0.5 μg of antibody per reaction).
Can I use the Kit to create more than 3 different Oligo-FlexLinkers?
Our protocols were validated and optimized for conjugation of minimum 10 nmol of oligo to 33 μg of Oligo-Ready FlexLinker. Using less can have disproportional impact on efficiency and yield.
Is purification required after conjugation?
After the final conjugation of the antibody with the Oligo-FlexLinker, no purification is needed. Remaining unbound FlexLinker is quenched by the FlexQuencher that is provided with the Kit. The protocol contains a clean-up step for removal of free oligo from the FlexLinker.
How can I verify successful conjugation?
We recommend taking samples during the conjugation protocol. Running an SDS PAGE can help you to estimate the conjugation efficiency and the yield of the Oligo-FlexLinker. We recommend doing a BCA assay to measure the concentration of the final product. Unfortunately, classical photometry will not give you precise results, as the oligo interferes with the measurement.
How stable are the products after preparation?
Oligo-FlexLinkers: After conjugation of the oligo to the FlexLinkers, this intermediate product is stable and can be stored for up to 6 months at -20°C, or up to 2 years at -80°C.
Labeled Antibodies after labeling a primary antibody with an Oligo-FlexLinker, complex stability strongly depends on the antibody that is labeled. We recommend labeling the antibody when you need it, the labeling process only takes 15 min. If you need to store the labeled antibody for longer, we recommend testing the product after storage to ensure proper functionality.
What storage conditions are recommended?
See above for recommended storage conditions for Oligo-FlexLinkers and labeled antibodies.
Is my oligo compatible with this technology?
FlexAble Oligo-Ready Kits are valid for a variety of different oligo lengths and types.
What are the FlexLinker, FlexQuencher and FlexBuffer?
The FlexLinker is a small polypeptide to which dyes are covalently conjugated that can label unconjugated primary antibodies. The FlexQuencher is a recombinant IgG or Fc fragment that neutralizes the excess FlexLinker. The FlexBuffer is a PBS-based buffer.
Do I need to remove unbound FlexLinker?
Unbound FlexLinker is neutralized by adding FlexQuencher. No additional removal step (e.g., by ultrafiltration) is required during the labeling process.
Will I observe cross-reactivity/leaking when I use two FlexAble-labeled antibodies from the same species during multiplexing?
FlexAble labels primary antibodies with a high affinity FlexLinker. Dissociation of FlexLinker from one antibody and association to another antibody is rare. If you observe leaking, we recommend adding more FlexQuencher to remove unbound FlexLinker, or you can try sequential staining of the labeled antibodies.
Does FlexAble Antibody Labeling Kit for Mouse IgG1 work with other mouse primary antibodies?
No, FlexAble Antibody Labeling Kit for Mouse IgG1 can only label mouse IgG1 primary antibodies since our kit is isotype specific.
What can I do to decrease background?
You can reduce the FlexQuencher amount or increase your washes after staining.
What is the highest concentration of my primary antibody that I can use?
There is no limitation for high concentrations of primary antibodies. If the concentration is very high and the volume to be pipetted is too small, you can dilute the antibody in PBS buffer to 0.5-1 mg/mL.
What is the lowest concentration of my primary antibody that I can use?
Our protocol uses 0.5 µg of primary antibody in 7 µL, which ends up at 0.07 mg/mL. If the concentration of your antibody is lower, you can also use a larger volume than 7 µL while using the same amount of FlexLinker and FlexQuencher.
Is it fine to freeze-thaw the reagents 50 times?
FlexAble kits remain functional, and the signal remains robust through freeze-thaw cycles, although aliquoting may increase shelf life.